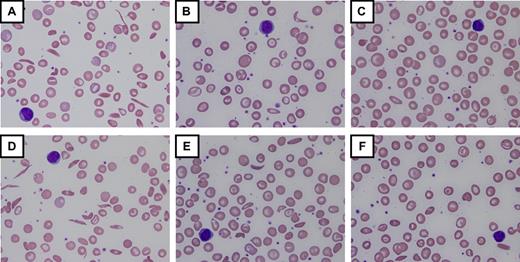
Figure 3. Laboratory and morphologic changes during hydroxyurea dose escalation to MTD. Increases in hemoglobin (Hb), mean corpuscular volume (MCV), and percentage fetal hemoglobin (HbF) occur simultaneously with decreases in white blood cell count (WBC), absolute neutrophil count (ANC), ARC, and lactate dehydrogenase (LDH). Morphologic changes to the erythrocytes include nonreticulocyte macrocytosis, increased numbers of target cells, fewer sickled forms, and relative “blunting” of the sickled cells that remain in circulation. (A-C) Changes from baseline through dose escalation to maximum tolerated dose (MTD) for a child with high HbF response (∼ 30% HbF at 30 mg/kg/d). (D-F) Changes for a child with low HbF response (∼ 15% HbF at 25 mg/kg/d). Despite the differences in HbF response, both patients have marked improvements in the peripheral blood smear morphology. For all panels, images were visualized using an Olympus BX40 microscope (Olympus America) with a 100×/1.25 numeric aperture oil-immersion objective (Resolve Microscope immersion oil, Thermo Scientific); photographs were taken with an Olympus DP20-SE digital camera, processed using Olympus DP2-BSW application software, and displayed using Microsoft Office PowerPoint 2003. Photographs courtesy of Nicole A. Mortier.

Abstract
Hydroxyurea has many characteristics of an ideal drug for sickle cell anemia (SCA) and provides therapeutic benefit through multiple mechanisms of action. Over the past 25 years, substantial experience has accumulated regarding its safety and efficacy for patients with SCA. Early proof-of-principle studies were followed by prospective phase 1/2 trials demonstrating efficacy in affected adults, then adolescents and children, and more recently infants and toddlers. The phase 3 National Heart, Lung and Blood Institute–sponsored Multicenter Study of Hydroxyurea trial proved clinical efficacy for preventing acute vaso-occlusive events in severely affected adults. Based on this cumulative experience, hydroxyurea has emerged as an important therapeutic option for children and adolescents with recurrent vaso-occlusive events; recent evidence documents sustained long-term benefits with prevention or reversal of chronic organ damage. Despite abundant evidence for its efficacy, however, hydroxyurea has not yet translated into effective therapy for SCA. Because many healthcare providers have inadequate knowledge about hydroxyurea, patients and families are not offered treatment or decline because of unrealistic fears. Limited support for hydroxyurea by lay organizations and inconsistent medical delivery systems also contribute to underuse. Although questions remain regarding its long-term risks and benefits, current evidence suggests that many young patients with SCA should receive hydroxyurea treatment.
Introduction
The pathophysiology of sickle cell anemia (SCA) arises from hemolytic anemia and acute vaso-occlusion; organ damage develops from recurrent erythrocyte sickling, chronic hemolysis, and progressive endothelial vasculopathy. Despite having a common genetic basis and similar pathophysiology, individual patients with SCA have a highly variable clinical phenotype. Among published predictors of clinical severity, the amount of fetal hemoglobin (percentage HbF) is the most critical laboratory parameter. HbF is protective against clinical severity; low-percentage HbF is associated with a higher risk of developing vaso-occlusive complications, organ damage, and early death.1,2 Accordingly, pharmacologic induction of HbF is a logical treatment goal in SCA, and recent reviews have focused on this topic.3,4 An increased white blood cell (WBC) count has also been associated with poor clinical outcomes,5,6 and more recently, elevated serum lactate dehydrogenase (LDH, reflecting intravascular hemolysis) has been associated with morbidity and mortality in SCA.7
Among several agents that lead to pharmacologic induction of HbF in patients with SCA, hydroxyurea has emerged as an exciting therapeutic agent because of its ease of oral administration, modest toxicity profile, predictable laboratory efficacy for increasing percentage HbF and reducing hemolysis, and proven clinical efficacy for preventing acute vaso-occlusive events. Hydroxyurea may also have a role for prevention and treatment of organ dysfunction, and these potential benefits are currently under active investigation. In this review designed for both pediatric and adult hematologists, I describe the rational use of hydroxyurea for children and adolescents with SCA, reflecting my opinion that hydroxyurea is an outstanding but currently underused treatment option for this young patient population.
Rationale for early treatment
It's not just about pain any more …
The painful vaso-occlusive event (often referred to as pain “crisis”) is the hallmark acute clinical manifestation of SCA, characterized by the sudden onset of discomfort. Often occurring without a specific trigger, pain typically presents in the chest, back, or extremities and requires hydration, analgesia, and frequent treatment, including hospitalization. Pain is common in SCA8 and often inadequately recognized and treated,9 but pain is not the whole picture and should not be considered the only clinical manifestation of SCA worth treatment or prevention. Other acute vaso-occlusive events include splenic sequestration, acute chest syndrome (ACS), and stroke, whereas others derive more from hemolytic anemia, such as pigmented bilirubin gallstones and jaundice. Additional clinical manifestations, such as priapism, leg ulcers, and possibly pulmonary hypertension, reflect the complex pathophysiology of SCA. Organ damage begins early in life and worsens over time but ultimately affects the brain, kidney, lung, spleen, bones, and eyes; the natural history culminates in early mortality.2,10 SCA is more properly recognized, therefore, as a chronic and progressively debilitating medical condition featuring ongoing hemolytic anemia and recurrent acute vaso-occlusive events, with considerable morbidity from insidious but inexorable organ damage. Accordingly, early treatment in young patients who have not yet developed serious or irreversible organ damage is a worthy goal.
The need for preventive therapy
Decades of observational data, including landmark natural history studies from the National Heart, Lung and Blood Institute (NHLBI)–sponsored Cooperative Study of Sickle Cell Disease and the Jamaican Sickle Cell Cohort, have documented SCA to be a severe, debilitating hematologic disorder. Although some patients have periods of relatively mild clinical severity, the typical patient with SCA exhibits multiple clinical manifestations from recurrent acute events and chronic organ dysfunction. Especially in the pediatric population, patients may be erroneously considered by their families and healthcare providers to be “doing well” if they are not having acute pain or currently requiring hospitalization. This is an inadequate and incorrect assessment; many of these patients have unrecognized disease manifestations, such as delayed growth and development, splenic dysfunction, chronic pain, nocturnal hypoxemia, neurocognitive delay, poor school performance, cerebrovascular and parenchymal brain damage, glomerular hyperfiltration, microalbuminuria, or perhaps even early pulmonary hypertension. Similar to analogous childhood medical conditions, such as juvenile diabetes, cystic fibrosis, and hemophilia, it is imperative to consider SCA in children and adolescents to be a chronic disorder warranting preventive therapy.
An ideal drug for SCA?
Pharmacotherapy for chronic medical conditions can be successful in clinical practice only if available therapeutic options have characteristics and features that offer treatment benefit while promoting medication adherence. For SCA, an ideal therapeutic intervention would require the following characteristics:
General features: single-agent, inexpensive, orally administered, once-daily dosing
Laboratory efficacy: increases HbF and total Hb, reduces WBC and reticulocytes, and lowers LDH
Clinical efficacy: ameliorates anemia, leads to fewer vaso-occlusive events and hospitalizations, decreases hemolysis
Treatment goals: works in all age groups, prevents acute events and chronic organ dysfunction
Sustainability: benefits continue over time without medication resistance or tolerance
Side effects: few short-term toxicities that might limit adherence, wide therapeutic index
Safety: no major short-term toxicities, plus no known long-term sequelae or complications of therapy
Based on currently available data, hydroxyurea treatment fulfills these criteria for SCA and should be offered much more frequently, especially to young patients before the development of chronic complications and end-organ damage. In the following sections, I summarize the published experience with hydroxyurea and then describe my personal approach to using this treatment option in young patients with SCA.
Use of hydroxyurea in SCA
Hydroxyurea time line
Clinical experience has been accumulating for more than 25 years regarding the safety and efficacy of hydroxyurea therapy for patients with SCA. Figure 1 illustrates a time line for hydroxyurea treatment in this patient population, beginning with early “proof-of-principle” studies in adults.11-14 In the early 1990s, an important prospective phase 1/2 study in adults15 using hydroxyurea at maximum tolerated dose (MTD) was followed by the pivotal NHLBI-sponsored double-blinded, placebo-controlled phase 3 MSH trial,16 which was halted early because of clinical efficacy for preventing vaso-occlusive events. Subsequently, reports described the short-term safety and efficacy for pediatric patients receiving open-label hydroxyurea treatment.17-20 The prospective NHLBI-sponsored phase 1/2 pediatric trial (HUG-KIDS)21 demonstrated that laboratory efficacy and toxicities of hydroxyurea were mild, and similar for children and adolescents as observed for adults with SCA.
Time line of hydroxyurea therapy for SCA. Clinical experience with hydroxyurea for patients with sickle cell anemia (SCA) has been accumulating for more than 25 years involving adults, children and adolescents, and even infants. Several multicenter randomized clinical trials are ongoing.
Time line of hydroxyurea therapy for SCA. Clinical experience with hydroxyurea for patients with sickle cell anemia (SCA) has been accumulating for more than 25 years involving adults, children and adolescents, and even infants. Several multicenter randomized clinical trials are ongoing.
In the recently completed decade, the time line is foreshortened with important studies published almost every year. The phase 1/2 HUSOFT trial reported that infants tolerate hydroxyurea (liquid formulation) without short-term adverse events and have substantial laboratory and clinical efficacy.22 Predictors of response to hydroxyurea in HUG-KIDS were published,23 along with evidence for normal growth and development.24 Sustained laboratory benefits were reported for school-age children25-27 and infants.28 Long-term clinical efficacy with reduced mortality has been reported with long-term hydroxyurea usage.29-31 More recently, salutary effects of hydroxyurea on organ function are being reported. NHLBI-sponsored prospective randomized clinical trials addressing the efficacy of hydroxyurea for prevention and treatment of organ dysfunction are currently under way; specific trials are described later.
Mechanisms of action
Given the abundant evidence for laboratory and clinical efficacy of hydroxyurea therapy in children and adults with SCA, it is perhaps surprising that its mechanisms of action for HbF induction remain incompletely understood. Current evidence suggests that several potential mechanisms of action by hydroxyurea may be relevant for patients with SCA, which together lead not only to HbF induction but also to additional benefits.
Perhaps the most important mechanism of action is inhibition of ribonucleotide reductase (RR), the enzyme involved in transforming ribonucleosides into deoxyribonucleosides that serve as building blocks for DNA synthesis.32 Hydroxyurea is a potent RR inhibitor that reduces intracellular deoxynucleotide triphosphate pools33 and acts as an S-phase–specific agent with inhibition of DNA synthesis and eventual cellular cytotoxicity.
Hydroxyurea directly inhibits the RR M2 subunit, but spontaneous regeneration of the active enzyme occurs when hydroxyurea is removed.34 For this reason, the in vivo effects of hydroxyurea on RR are predictably transient, resulting from the rapid absorption, metabolism, and excretion of hydroxyurea in mammalian systems. Presumably with once-daily dosing in SCA, hydroxyurea causes intermittent cytotoxic suppression of erythroid progenitors and cell stress signaling,35 which then affects erythropoiesis kinetics and physiology and leads to recruitment of erythroid progenitors with increased HbF levels. Additional mechanisms of action for HbF induction have been proposed for hydroxyurea, including free radical formation, iron chelation, activation of soluble guanylyl cyclase, and direct nitric oxide (NO) production.36-39
Multiple benefits for SCA
A remarkable attribute of hydroxyurea is the observation that treatment has multiple potential benefits for patients with SCA (Figure 2). Beyond HbF induction, the cytotoxic effects of hydroxyurea also reduce marrow production of neutrophils and reticulocytes. Because an elevated WBC has been associated with both morbidity and mortality of SCA,1,2,5,6 lowering the WBC count in SCA is itself potentially therapeutic. Both neutrophils and reticulocytes promote vaso-occlusion through vascular adhesion; hydroxyurea lowers their absolute numbers and reduces surface expression of adhesion receptors.40-42
Multiple beneficial effects of hydroxyurea for SCA. (1) Fetal hemoglobin induction through soluble guanylyl cyclase activation and altered erythroid kinetics; (2) lower neutrophil and reticulocyte counts from ribonucleotide reductase inhibition and marrow cytotoxicity; (3) decreased adhesiveness and improved rheology of circulating neutrophils and reticulocytes; (4) reduced hemolysis through improved erythrocyte hydration, macrocytosis, and reduced intracellular sickling; and (5) Nitric oxide (NO) release with potential local vasodilatation and improved vascular response. Illustration courtesy of Alice Y. Chen.
Multiple beneficial effects of hydroxyurea for SCA. (1) Fetal hemoglobin induction through soluble guanylyl cyclase activation and altered erythroid kinetics; (2) lower neutrophil and reticulocyte counts from ribonucleotide reductase inhibition and marrow cytotoxicity; (3) decreased adhesiveness and improved rheology of circulating neutrophils and reticulocytes; (4) reduced hemolysis through improved erythrocyte hydration, macrocytosis, and reduced intracellular sickling; and (5) Nitric oxide (NO) release with potential local vasodilatation and improved vascular response. Illustration courtesy of Alice Y. Chen.
Additional benefits of hydroxyurea treatment include salutary effects on the circulating erythrocytes (Figure 2). A frequently observed effect of hydroxyurea treatment is an elevated mean corpuscular volume (MCV), despite reduced reticulocytosis. Peripheral erythrocytes undergo numerous morphologic and physiologic changes during hydroxyurea dose escalation to MTD, including macrocytosis, increased mean corpuscular hemoglobin, better hydration, more targeting, less hemolysis, and fewer sickled forms. Overall blood flow is improved, with a higher hemoglobin concentration and lower LDH and bilirubin levels. Concerns about deleterious effects related to a higher hemoglobin concentration causing higher blood viscosity do not appear clinically relevant, presumably because of counteracting benefits from increased cellular hydration and deformability, decreased adhesiveness, and overall improved rheology.
Finally, the hydroxyurea molecule contains an NO moiety that can be released directly through unknown metabolic processes.43 NO has beneficial effects on vascular endothelium, including local vasodilatation, and could help offset proposed hemolysis-related NO consumption.44 This effect may help explain the clinical improvement some patients feel soon after initiating hydroxyurea treatment, before reaching MTD with maximal HbF induction.
Short-term safety and efficacy
Laboratory responses
In adults with SCA, daily hydroxyurea at MTD leads to significant increases in percentage HbF, MCV, and Hb as well as decreases in WBC, neutrophils, and reticulocytes.15 Similar laboratory efficacy for hydroxyurea therapy is observed in children and adolescents. In the phase 1/2 HUG-KIDS trial, 84 school-aged children with severe clinical manifestations (median age, 9.1 years) received open-label hydroxyurea; 68 reached MTD, including 52 at MTD for 1 year. Hydroxyurea led to significant increases in percentage HbF, Hb, and MCV along with significant decreases in WBC, reticulocytes, and LDH.21 Remarkably similar laboratory responses were observed in the prospective phase 1/2 trials of adults and children with SCA (Table 1).
To date, most US studies have escalated hydroxyurea to MTD, whereas studies from Europe have used lower dosing regimens intended to achieve clinical therapeutic benefit without escalation to MTD. Table 2 summarizes laboratory responses to hydroxyurea, separating studies targeting MTD. In general, trials with escalation to MTD have reported higher percentage HbF, as well as higher hemoglobin and MCV.
Expected toxicities
Side effects of hydroxyurea therapy in young patients with SCA are usually mild, and most children tolerate hydroxyurea without difficulty. Occasionally, patients will describe headache or mild gastrointestinal symptoms, including abdominal discomfort or nausea.21 Some children develop dermatologic changes, including skin hyperpigmentation or darkening of the nails (melanonychia), which are sporadic and not dose-dependent.45 Although skin ulcers have been reported rarely in adults with myeloproliferative disorders receiving hydroxyurea, this toxicity occurred equally in both MSH treatment arms.16 Hepatic and renal dysfunction from hydroxyurea treatment has not been reported.
Clinical experience confirms that the most common short-term hydroxyurea toxicity in patients with SCA is transient and reversible myelosuppression, primarily neutropenia, although in some young patients reticulocytopenia can be dose-limiting.21,46 Marrow suppression and mild peripheral blood cytopenias represent predictable toxicities of daily hydroxyurea therapy and are actually desired effects during escalation to MTD.21,26,46 Neutropenia is the most common laboratory toxicity, but its incidence depends on the absolute neutrophil count (ANC) threshold used for toxicity and dose adjustments (usually 1.0-2.0 × 109/L); severe cytopenia is rare. Table 3 illustrates the cumulative incidence of short-term laboratory toxicities associated with hydroxyurea therapy at MTD in HUG-KIDS.21 Even with the conservative ANC toxicity threshold used (2.0 × 109/L), little toxicity was observed.
The phase 1/2 HUSOFT pilot study documented feasibility of hydroxyurea for very young children with SCA between the ages of 6 and 24 months and evaluated its safety and toxicity profile. Twenty-eight infants with HbSS at 4 centers were enrolled in an open-label study; the fixed hydroxyurea dose of 20 mg/kg/d was well tolerated with few hematologic toxicities.22 An extension study on these patients with hydroxyurea dose escalation to MTD did not reveal additional toxicities.28
Clinical efficacy
The clinical efficacy of hydroxyurea for acute vaso-occlusive events was proven for adults with SCA in MSH.16 Similar efficacy has been reported in small series of children with SCA17,19,47 ; usually, the number of painful events is reduced, along with hospitalizations. Experience in Europe has supported the observation that acute complications are reduced in both number and severity.18,20,25,27 In practice, most children with good hydroxyurea adherence have impressive clinical improvement, often before maximal laboratory changes occur. Accordingly, a double-blinded “pediatric MSH” will probably never occur; current clinical experience makes a placebo-controlled trial focusing on acute vaso-occlusive events as the primary endpoint almost unethical for children with SCA. However, the phase 3 infant hydroxyurea trial (BABY HUG) will provide prospective evidence about acute events in a large cohort of young patients randomized to either hydroxyurea or placebo; similar clinical efficacy would be predicted.
Evidence for the efficacy of hydroxyurea in protecting or preserving organ function in SCA is steadily emerging. An early report described regeneration of splenic function.48 In HUSOFT, infants receiving hydroxyurea had preservation of splenic function, as measured by radionuclide uptake, compared with historical controls.22 Subsequent reports, usually single institution experiences, suggest that hydroxyurea has clinical efficacy for children with variable sickle-related organ damage, including proteinuria,49 spleen dysfunction,50 hypoxemia,51 pulmonary hypertension,52 glomerular hyperfiltration,53 neurocognitive delay,54 silent brain infarcts,49 elevated transcranial Doppler (TCD) velocities,53,55,56 primary stroke prevention,56,57 and secondary stroke prevention.58,59 Based on these encouraging but uncontrolled reports, several prospective multicenter randomized trials using hydroxyurea to prevent organ dysfunction in SCA are currently under investigation.
Long-term safety and efficacy
Sustained benefits
The laboratory efficacy of hydroxyurea usually becomes evident during dose escalation and is well established on reaching a stable MTD. Laboratory benefits are then sustained when children with SCA are adherent with therapy. In our retrospective analysis of open-label treatment, the average HbF for a large cohort of pediatric patients was 20% after 7 years of follow-up.26 Similarly, the HUSOFT extension documented sustained HbF levels, averaging 20% at 6 years after hydroxyurea initiation.28
In both school-age and very young patients with SCA, open-label hydroxyurea has been associated with excellent growth and development,24,26,28 sometimes with patients even crossing growth percentiles in an upward fashion. Sexual maturation, including menarche, has occurred without apparent delay.21,24 For toddlers on open-label hydroxyurea, impact-on-family scores improved after 2 years of treatment.53 Long-term clinical benefits have also been observed with fewer painful events and hospitalizations.26,27 For adults with SCA enrolled in MSH, long-term exposure to hydroxyurea was associated with significantly reduced mortality29 and improved quality of life.60 These latter findings are remarkable because adult MSH patients had decades of accumulated complications before enrollment. Recently, a 17-year single-institution trial using hydroxyurea in adults with SCA (HbSS or HbS/β-thalassemia) to treat acute vaso-occlusive events documented significantly less mortality compared with untreated patients.31 Taken together, published reports document sustained laboratory and clinical benefits for some patients with SCA who receive long-term hydroxyurea treatment, including prolonged survival and improved quality of life.
Effects on pregnancy and fertility
Because hydroxyurea is an S-phase agent that inhibits DNA replication, it could potentially have adverse effects on both fertility and pregnancy outcomes. An exhaustive summary on the toxicity of hydroxyurea did not document known effects on either fertility or pregnancy in humans.61 However, a recent publication reported abnormal sperm parameters in adult males with SCA on hydroxyurea therapy,62 which could cause either infertility or teratogenicity. In that retrospective analysis, most patients had abnormal sperm counts or function before starting hydroxyurea, making it difficult to determine the contribution of hydroxyurea to the abnormal findings. Prospective studies in young males with pretreatment and posttreatment sperm analyses will be necessary to answer this question definitively.
The only prospective data regarding the effects of hydroxyurea during pregnancy in SCA derive from 94 pregnancy outcomes among subjects enrolled in MSH and its follow-up study.63 Although not formally case-controlled, this long-term prospective cohort had a large number of normal pregnancy outcomes, suggesting that fetal exposure to therapeutic doses of hydroxyurea does not cause teratogenic changes in pregnancies that result in live births, whether full term or premature.63 This seems to be true whether the parent taking hydroxyurea was the mother or father, and regardless of the timing of hydroxyurea exposure during the pregnancy, that is, during conception, gestation, or throughout.63
Risk of malignancy
Perhaps the greatest fear regarding hydroxyurea for patients with SCA, particularly children who might receive decades of treatment, is the possibility of mutagenicity and carcinogenicity. Because hydroxyurea reduces intracellular deoxynucleoside triphosphate pools,32,33 it affects not only DNA synthesis required for cell division but also DNA repair. In vitro, DNA damage that develops spontaneously or from environmental mutagens cannot be fully repaired in the presence of hydroxyurea, possibly leading to in vivo accumulation of somatic mutations and chromosomal damage.64 Our limited study of children and adults receiving hydroxyurea treatment did not identify clear evidence of genotoxicity but concluded that longer follow-up was needed.65
Anecdotes have been published describing young patients with SCA who developed malignancy while taking hydroxyurea therapy.66-68 In at least one instance, the association should not be considered causal because of the short interval of treatment,69 whereas in others the association was possibly linked. However, cases of cancer in SCA were reported before hydroxyurea therapy became available,70,71 including the first successful bone marrow transplantation for SCA in a child who developed acute myeloid leukemia.72 In a retrospective survey by the International Association of Sickle Cell Nurses and Physician Assistants, 52 cases of cancer were identified in a cohort of more than 16 000 patients with SCA.73 Almost all occurred in the prehydroxyurea era; only 3 patients had previous hydroxyurea exposure. Among children with SCA, 21 reported cancers included leukemia (n = 7), Wilms tumor (n = 5), lymphoma (n = 3), and 6 other solid tumors; only 1 patient with acute lymphoblastic leukemia had previous hydroxyurea exposure. Based on tens of thousands of exposure years now accumulated, hydroxyurea used at therapeutic doses in young patients with SCA does not appear to confer an increased risk of malignancy.
My approach using hydroxyurea
My personal use of hydroxyurea therapy for young patients with SCA began in 1993, and my clinical and practical approach has been shaped by experience with more than 500 patients, either treating in research trials or using best clinical practice guidelines. A summary of this approach was recently published as a clinician's “user's guide”46 ; the following summarizes some salient features related to patient selection, optimal dosing, risks and benefits, and adherence.
Identifying patients
Young patients with SCA who develop acute vaso-occlusive complications, especially recurrent painful events or ACS, are ideally suited for hydroxyurea treatment. These children and adolescents, as well as their families, are naturally motivated to use hydroxyurea to help prevent acute complications. Although early clinical trials required a certain number or frequency of these events for eligibility, it now seems illogical to limit therapy in practice based on strict criteria. At my institution, hydroxyurea is currently offered to children with pain or ACS as young as 2 years old; infants with SCA are not currently treated, pending safety and toxicity data from the BABY HUG trial.
Hydroxyurea should also be considered for young patients with few acute clinical events but abnormal laboratory parameters. Low hemoglobin and percentage HbF, as well as elevated WBC and LDH, are associated with adverse clinical outcomes1,2,5,7 ; hydroxyurea will have salutary effects and add laboratory benefits to the clinical efficacy. Another emerging category for treatment consideration is early evidence of organ dysfunction, such as hypoxemia, microalbuminuria, or elevated TCD velocities. Although benefits of hydroxyurea for preventing organ damage are not yet proven, accumulating anecdotal evidence supports this consideration. Finally, families themselves are increasingly requesting hydroxyurea; sometimes one child receives therapy but not a younger sibling, and occasionally interest is based on educational information or even “word-of-mouth” from other families.
Based on cumulative data regarding the efficacy of hydroxyurea for SCA, coupled with an increasing level of comfort for its use among healthcare providers and increased education of families, my institution has adopted consensus criteria regarding the initiation of hydroxyurea therapy for young patients (Table 4). Currently, children older than 24 months with severe forms of SCA (eg, HbSS, HbS/β0-thalassemia) are offered treatment for clinical or laboratory indications. Clinical indications include acute vaso-occlusive events and evidence of early chronic organ dysfunction. Individual case-by-case decisions are made with families with special circumstances, such as a sibling on therapy. Treatment criteria are modified periodically based on new data and published literature, and so, cannot be considered static or firm guidelines. In the near future, the diagnosis of SCA may itself become sufficient to warrant discussion and initiation of hydroxyurea therapy.
Dose initiation and escalation
Children and adolescents can be safely started at 20 mg/kg/d orally with blood counts checked every 4 weeks. Occasionally, this dose causes rapid myelosuppression (neutropenia or reticulocytopenia) warranting medication review or dose reduction. In most patients, however, 20 mg/kg/d is well tolerated, and dose escalation by 5 mg/kg/d can then occur at 8-week intervals; more rapid dose escalation may result in cumulative hematologic toxicity not initially apparent. At each visit, it is necessary to check current blood counts but also analyze trends from previous values.
Patients are escalated to MTD based on laboratory results reflecting modest myelosuppression, typically targeting ANC 2.0 to 4.0 × 109/L and absolute reticulocyte count (ARC) 100 to 200 × 109/L. Using this strategy, most children achieve MTD in 6 to 8 months, averaging 25 to 30 mg/kg/d.26,46 After 12 months of hydroxyurea treatment, maximal laboratory effects are reached.21,46 Despite what is reported for some adults, there are few, if any, pediatric “nonresponders” to hydroxyurea; in my experience, every child with SCA who swallows the medication has increased percentage HbF and other expected laboratory changes, although considerable variation is observed among individual patients. Figure 3 includes peripheral blood smears and laboratory results for 2 HbSS children, illustrating similarities and differences occurring during escalation to MTD. In some cases, hydroxyurea at 30 to 35 mg/kg/d may be required for maximal benefit; however, these higher doses should be prescribed only when adherence is carefully addressed to avoid toxicity in a suddenly adherent patient.
Laboratory and morphologic changes during hydroxyurea dose escalation to MTD. Increases in hemoglobin (Hb), mean corpuscular volume (MCV), and percentage fetal hemoglobin (HbF) occur simultaneously with decreases in white blood cell count (WBC), absolute neutrophil count (ANC), ARC, and lactate dehydrogenase (LDH). Morphologic changes to the erythrocytes include nonreticulocyte macrocytosis, increased numbers of target cells, fewer sickled forms, and relative “blunting” of the sickled cells that remain in circulation. (A-C) Changes from baseline through dose escalation to maximum tolerated dose (MTD) for a child with high HbF response (∼ 30% HbF at 30 mg/kg/d). (D-F) Changes for a child with low HbF response (∼ 15% HbF at 25 mg/kg/d). Despite the differences in HbF response, both patients have marked improvements in the peripheral blood smear morphology. For all panels, images were visualized using an Olympus BX40 microscope (Olympus America) with a 100×/1.25 numeric aperture oil-immersion objective (Resolve Microscope immersion oil, Thermo Scientific); photographs were taken with an Olympus DP20-SE digital camera, processed using Olympus DP2-BSW application software, and displayed using Microsoft Office PowerPoint 2003. Photographs courtesy of Nicole A. Mortier.
Laboratory and morphologic changes during hydroxyurea dose escalation to MTD. Increases in hemoglobin (Hb), mean corpuscular volume (MCV), and percentage fetal hemoglobin (HbF) occur simultaneously with decreases in white blood cell count (WBC), absolute neutrophil count (ANC), ARC, and lactate dehydrogenase (LDH). Morphologic changes to the erythrocytes include nonreticulocyte macrocytosis, increased numbers of target cells, fewer sickled forms, and relative “blunting” of the sickled cells that remain in circulation. (A-C) Changes from baseline through dose escalation to maximum tolerated dose (MTD) for a child with high HbF response (∼ 30% HbF at 30 mg/kg/d). (D-F) Changes for a child with low HbF response (∼ 15% HbF at 25 mg/kg/d). Despite the differences in HbF response, both patients have marked improvements in the peripheral blood smear morphology. For all panels, images were visualized using an Olympus BX40 microscope (Olympus America) with a 100×/1.25 numeric aperture oil-immersion objective (Resolve Microscope immersion oil, Thermo Scientific); photographs were taken with an Olympus DP20-SE digital camera, processed using Olympus DP2-BSW application software, and displayed using Microsoft Office PowerPoint 2003. Photographs courtesy of Nicole A. Mortier.
Hydroxyurea is commercially available in 200-, 300-, 400-, and 500-mg capsules. Combinations of capsules help target specific doses, aiming for a structured dose initiation and escalation process to a stable MTD.46 Liquid formulations allow dose fine-tuning and are useful for younger patients who cannot swallow capsules. Liquid hydroxyurea formulations are typically prepared extemporaneously because no commercial product currently exists. Hydroxyurea at 100 mg/mL is stable with efficacy in clinical trials22,28,53 and normal home use.26 Refrigeration is recommended, but liquid hydroxyurea formulations are stable at room temperature if temperature excursions do not occur; overheating reduces the drug's chemical and functional effects.74
A frequent question relates to the merits of increasing the hydroxyurea dose to MTD, instead of using a lower but clinically effective dose. Although some clinical and laboratory benefits may occur at lower doses, I think the daily dose should be escalated and then maintained at MTD, recognizing that not all children will tolerate 25 to 30 mg/kg/d and MTD may vary over time depending on weight gain, body fat, renal function, and puberty. Because the beneficial effects of hydroxyurea on laboratory parameters are dose-dependent92 and “more is better” when considering the therapeutic benefits of HbF induction, the optimal hydroxyurea dose is what achieves maximal HbF without hematologic or other toxicities. As noted earlier (Table 2), studies using hydroxyurea at MTD typically achieve higher percentage HbF values than lower doses.
Short-term concerns
Hydroxyurea is usually well tolerated by young patients with SCA with few short-term toxicities. Because hydroxyurea is an oral medication, its potency can be overlooked; patients and families should be reminded that hydroxyurea effects are not immediately obvious but still powerful. Doses should be taken at approximately the same time each day to promote adherence, but exact times are irrelevant. Capsules are tasteless but fairly large, and some children prefer liquid formulations even into teenage years. Occasionally, patients describe gastrointestinal discomfort; when persistent, changing the daily dose from morning to evening may help reduce symptoms. Although uncommon, skin and nail pigmentation changes are cosmetic and rarely bothersome to patients or families.
Long-term concerns
Although short-term hydroxyurea toxicities are typically mild and well tolerated by most pediatric patients with SCA, long-term risks associated with hydroxyurea are incompletely defined, particularly for children who could receive prolonged and perhaps lifelong treatment. However, because treatment duration now approaches 12 to 15 years in some children and adolescents and cumulative patient-years worldwide probably number in the tens of thousands, major concerns about serious long-term consequences are starting to diminish at many academic programs. A national registry of patients on hydroxyurea would be very helpful to gauge the incidence of unusual adverse events but does not currently exist. In my clinical experience, long-term hydroxyurea treatment is well tolerated and adherent children have continued laboratory efficacy,26 with no evidence supporting the concept of pharmacologic tolerance or resistance.
Potential long-term risks of hydroxyurea should be discussed carefully with families but put into perspective. Specifically, risks of hydroxyurea must be compared with risks of untreated SCA; the natural history of clinically severe SCA is well known with a poor prognosis.1,2,5,6 Probably the 2 most important long-term risks for families and healthcare providers relate to potential treatment-related infertility or cancer. The former is discussed using available information, including the recent publication describing no relationship between hydroxyurea usage and neonatal abnormalities or teratogenic effects.31 The latter issue, in contrast, is more complex and requires both an academic and experiential perspective.
Anecdotes of cancer developing in young patients with SCA on hydroxyurea therapy have been reported.68-70 However, patients with SCA can develop cancer like the rest of the general population.71-73 In my own experience, 2 cases of malignancy (acute myeloid leukemia and retinoblastoma) were recognized just before starting hydroxyurea therapy, which highlights the dangers of assuming causality. A registry of patients with SCA receiving hydroxyurea will be required to define the cancer risk accurately; until then, anecdotes of malignancy in SCA should be viewed cautiously.
Adherence
Most approaches for improving medication adherence are educational, including frequent reminders about the rationale for therapy, desired effects of treatment, and consequences of nonadherence. Frequent reviews of the medication name, daily dose, time of administration, and pill counts are practical and common-sense approaches. Additional efforts, such as medication calendars, pill containers, and encouragement from family members, also can be beneficial. A more novel approach, which is both gratifying and effective, is to routinely show the patient's own serial peripheral blood smears to the child and family members during outpatient clinic visits, using a multiheaded microscope.46 Because hydroxyurea does not typically have beneficial or harmful short-term effects, seeing morphologic blood cell changes from baseline to MTD (Figure 3) helps patients and families realize that hydroxyurea is actually working by improving anemia, altering morphology, and reducing circulating sickled cells. Much work remains, however, to optimize adherence to hydroxyurea in young patients with SCA.
Effectiveness: putting hydroxyurea into practice
An important challenge for healthcare providers is translating results from controlled clinical trials into everyday clinical practice. In the case of hydroxyurea for SCA, abundant evidence has accumulated from dozens of publications documenting the efficacy of hydroxyurea in this patient population. However, taking that information and applying it to patients outside of a clinical trial require substantial clinical infrastructure, careful programmatic planning, and extensive educational efforts.
Evidence for effectiveness
How well can hydroxyurea work in actual practice? The effectiveness of long-term open-label hydroxyurea treatment on laboratory parameters for 111 children with SCA receiving hydroxyurea at MTD is summarized in Table 5. The average hydroxyurea dose at MTD was 26.8 plus or minus 3.2 mg/kg/d (median, 27.1 mg/kg/d; range, 13.9-31.1 mg/kg/d). With frequent educational reminders and aggressive involvement by attending physicians and midlevel healthcare providers, treatment adherence was deemed excellent (defined as > 80% taken) for 95 patients (86%), based on returned capsules or liquid hydroxyurea; the 16 remaining patients (14%) had lower adherence despite frequent education and reminders. Composite results illustrate highly significant changes in many laboratory parameters: increases in Hb, MCV, and percentage HbF, along with decreases in ARC, WBC, ANC, total bilirubin, and LDH (all P < .001). Clinical effects were equally convincing: hospital admissions for pain and other vaso-occlusive episodes decreased compared with prehydroxyurea data. It should be emphasized, however, that expanding hydroxyurea use requires administrative planning, including adequate provider training and staffing. Changing patients from 2 or 3 visits to 10 to 12 visits per year for hydroxyurea monitoring requires additional infrastructure for optimal effectiveness.
Despite abundant published data regarding the laboratory and clinical efficacy of hydroxyurea for children and adults with SCA, many providers do not prescribe it for patients who might benefit. A survey of adult hematologists revealed that few practicing physicians felt comfortable managing hydroxyurea in adult patients.75 Hydroxyurea has not decreased the number of hospitalizations for SCA,76 despite evidence that its use is cost-effective.77 Paradoxically, the efficacy of hydroxyurea in clinical trials is quite clear, yet its effectiveness in clinical practice has not been realized. What are the barriers to hydroxyurea therapy and why do they exist?
National Institutes of Health Consensus Conference
In 2007, the NHLBI held a planning committee meeting to investigate barriers to hydroxyurea therapy in SCA. After months of planning and a thorough literature review supported by the Agency for Healthcare Research and Quality (AHRQ), the NHLBI convened a formal Consensus Development Conference in February 2008. An independent panel of health professionals and public representatives reviewed the AHRQ review, listened to presentations, heard questions and discussions, and then held closed deliberations. The AHRQ reports78,79 and Consensus Development Conference Statement80 are now published; these documents detail the medical knowledge and assessment of hydroxyurea treatment for patients with SCA. Strong evidence for efficacy among adults and adolescents is described, acknowledging that less strong but supportive evidence exists for infants and children. In the discussion of harms of hydroxyurea treatment, the panel wrote, “The risks of hydroxyurea are acceptable compared with the risks of untreated sickle cell disease,”80 which succinctly summarizes my own discussions with families who are considering hydroxyurea treatment for their child.
The Consensus Statement also included discussion of barriers to hydroxyurea treatment at 4 levels: patient, parent/family/caregiver, provider, and system. Education about benefits of hydroxyurea and support for patients, families, and communities can help increase treatment; advocacy from lay organizations promoting hydroxyurea use is noticeably lacking. However, system-level barriers related to insurance, medical access, and lack of knowledgeable providers have no easy solutions.81 Although hydroxyurea is inexpensive and requires relatively simple monitoring, issues related to public and private third-party payers still exist.80,81 The consensus statement concluded that hydroxyurea is an important major advance in the treatment of SCA, risks of harm are reassuring and are acceptable compared with no treatment, and barriers to its effectiveness in everyday practice must be addressed to relieve the burden of suffering and improve quality of life among persons with SCA.80
Current clinical trials
As of January 2010, several NHLBI-sponsored clinical trials include hydroxyurea treatment for children with sickle cell disease (Table 6). The primary objectives of each trial have the opportunity to alter management and potentially increase hydroxyurea use.
Hydroxyurea to Prevent Organ Damage in Children with Sickle Cell Anemia (BABY HUG, NCT00006400), a phase 3 double-blinded, placebo-controlled, multicenter randomized clinical trial testing the hypothesis that hydroxyurea can prevent organ damage in very young patients with SCA. Hydroxyurea is given at a fixed dose of 20 mg/kg/d for 24 months, and primary endpoints include splenic and renal function. The treatment phase in BABY HUG is now closed with results expected in 2010.
Stroke With Transfusions Changing to Hydroxyurea (SWiTCH, NCT00122980) trial is a phase 3 multicenter randomized clinical trial for children with SCA, previous stroke, and transfusional iron overload. Alternative treatment (hydroxyurea and phlebotomy) is compared with standard treatment (transfusions and chelation) for the prevention of recurrent stroke and management of iron overload, respectively. Enrollment in SWiTCH was completed in March 2009 with primary study results expected in late 2011.
Long-Term Effects of Hydroxyurea Therapy in Children With Sickle Cell Disease (HUSTLE, NCT00305175) is an observational and longitudinal trial at St Jude Children's Research Hospital. Data are prospectively gathered on hydroxyurea pharmacokinetics, genotoxicity, and long-term effects on organ function. Approximately 170 of 300 planned patients are enrolled to date.
Evaluating the Safety and Effectiveness of Hydroxyurea and Magnesium Pidolate to Treat People With Hemoglobin Sickle Cell Disease (CHAMPS, NCT00532883). This multicenter trial evaluated the combination of hydroxyurea and magnesium pidolate for patients with HbSC disease; CHAMPS was terminated in late 2008 because of inadequate study enrollment, but collected study data should be published in 2010.
TCD With Transfusions Changing to Hydroxyurea (TWiTCH) is a phase 3 multicenter randomized clinical trial for children with SCA and abnormal TCD velocities. TWiTCH will compare hydroxyurea with transfusions for maintaining TCD velocities and preventing primary stroke; enrollment is scheduled to begin in mid-2010.
Future research direction
Despite the continued and growing clinical experience with hydroxyurea therapy for children with SCA, several important areas deserve further research and investigation.
Understanding phenotypic variability
Laboratory responses to hydroxyurea therapy in children with SCA are predictably beneficial yet highly variable. With good adherence at MTD, percentage HbF will always increase, but the HbF response varies from 10% to more than 30%.21,26,46 Similar variable responses to hydroxyurea occur with other laboratory parameters, including hemoglobin, MCV, and LDH. This interindividual variability in hydroxyurea response is illustrated in Figure 4, which includes percentage HbF and LDH values at MTD for 95 highly adherent children. Despite published associations with HbF response,23 clinicians cannot predict accurately which child will be a low, medium, or high HbF responder, defined operationally as less than 20%, 20% to 30%, and more than 30% HbF at MTD, respectively. Newly described genetic predictors of baseline percentage HbF82,83 may help predict the treatment HbF response. Understanding the phenotypic variability would help decision-making for clinicians and families. At the current time, without clear laboratory or genetic predictors of response, all eligible children with SCA should be considered for hydroxyurea treatment regardless of their baseline laboratory values.23
Interindividual variation in response to hydroxyurea treatment. Data are shown for 95 children with SCA treated at St Jude Children's Research Hospital, judged to be more than 80% adherent to hydroxyurea therapy. (A) Percentage HbF response, showing a broad distribution of percentage HbF values at hydroxyurea MTD, ranging from approximately 10% to more than 40%. (B) LDH response again showed a broad distribution of values at hydroxyurea MTD (normal < 310 U/L). Data analysis and graphs courtesy of Dr Cheng Cheng.
Interindividual variation in response to hydroxyurea treatment. Data are shown for 95 children with SCA treated at St Jude Children's Research Hospital, judged to be more than 80% adherent to hydroxyurea therapy. (A) Percentage HbF response, showing a broad distribution of percentage HbF values at hydroxyurea MTD, ranging from approximately 10% to more than 40%. (B) LDH response again showed a broad distribution of values at hydroxyurea MTD (normal < 310 U/L). Data analysis and graphs courtesy of Dr Cheng Cheng.
Hydroxyurea pharmacogenetics
Pharmacokinetics and pharmacodynamics of hydroxyurea treatment for children with SCD have documented interpatient variability, with coefficients of variation for most pharmacokinetic parameters exceeding 30%.84 As hydroxyurea use becomes more common in SCA, better understanding of the pharmacokinetics and pharmacodynamics is needed, particularly among young patients. Genetic variation probably has important influences on hydroxyurea; candidate genes affecting drug absorption, metabolism, and clearance, as well as therapeutic cellular effects, are critical to identify at this time.85 Investigation into genetic modifiers affecting hydroxyurea response is actively underway at several laboratories and is a primary objective of the HUSTLE protocol (Table 6).
Effectiveness and adherence
As noted in the National Institutes of Health Consensus Statement, moving from the efficacy of hydroxyurea in clinical trials to effectiveness in clinical practice remains a formidable challenge; barriers must be identified and addressed at many levels. First, education of healthcare providers must be emphasized to ensure that accurate information is available to patients and families. With interest in hydroxyurea increasing, patients should be empowered to make informed choices about its use; most will probably choose hydroxyurea over other treatment choices.86 Decision-making research is needed to clarify the risks and benefits of treatment for children who have different degrees of clinical severity.
As more patients initiate hydroxyurea treatment, healthcare systems must be prepared to provide appropriate monitoring and support. Particularly if current clinical trials such as BABY HUG confirm safety and document efficacy for acute vaso-occlusive events such as pain and ACS, or suggest new clinical efficacy for preventing organ damage, hydroxyurea treatment will become even more attractive. The ideal age to initiate hydroxyurea in SCA is not yet defined, but physiologic HbF declines suggest that preventive treatment should begin early in life.87 All hematologists whose practice includes patients with SCA should begin thinking now about the logistics of expanding hydroxyurea use, anticipating that it may eventually become accepted as standard therapy to be offered to all young patients with SCA.
Means of improving adherence are also needed. Education and behavioral modifications have limited effects over time. Regular review of the blood smear with patients represents one effective method of maintaining or improving adherence,46 but additional creative approaches are needed. The use of school personnel including nurses may help certain families and patients. With current technologic advances, electronic or telephonic (text message) notifications and reminders should also be considered.
International opportunities
Much has been written about the need to promote better collaborations between developed and developing nations for the treatment of patients with SCA.88,89 The new NHLBI Strategic Plan emphasizes SCA and the need for international cooperation.90 Because hydroxyurea is very inexpensive compared with most drug treatments, and generic forms of hydroxyurea have documented efficacy,91 treatment should be strongly considered for children in developing countries. A straightforward safety and efficacy trial of hydroxyurea in young patients with SCA in developing countries would be an important first step toward improved use of this agent. Comparative effectiveness research should investigate outcomes of hydroxyurea treatment across diverse patient populations, including international subgroups.
Variant genotypes
Almost all of the data discussed in this article derive from studies on patients with severe forms of SCA (typically homozygous HbSS and occasionally HbS/β0-thalassemia); in comparison, data on safety and efficacy for patients with genotypic variants, such as HbSC or HbS/β+-thalassemia, are scant. Anecdotes of laboratory and clinical improvement have been reported,92-94 but no recent prospective trials have been completed. A safety and efficacy phase 2 trial in patients with HbSC would be an important study to design and complete in the near future, perhaps using hemoglobin, percentage dense cells, or even total blood viscosity as the primary study endpoints.
Final considerations
As we mark the 100-year anniversary of the first published report,95 there should be no doubt within the medical community that SCA is a catastrophic disease affecting children, adolescents, and adults. With protean and serious clinical manifestations, many of which are insidious but progressive, SCA must be viewed as a chronic medical condition that merits early and aggressive therapy. No longer should it be acceptable to describe children and adolescents with SCA as “doing well” just because they are pain-free or not hospitalized. Instead, hematologists should recognize that young patients with SCA have a chronic condition requiring ongoing therapy to prevent disease complications.
We do not treat diabetes simply to avoid ketoacidosis, or asthma just to avert intubation; similarly, we should not treat SCA with the goal of simply reducing acute complications requiring hospitalization. As hematologists, we owe our patients with SCA the opportunity to enjoy healthy and productive lives with good quality. We should make every effort to treat children and adolescents with SCA before they develop chronic, inexorable, and ultimately fatal organ damage. The recent observation that mortality rates for older children with SCA have not changed in 20 years96 indicates the need for new approaches to disease management, especially regarding therapeutic intervention. At the current time, curative therapy with stem cell transplantation remains an unavailable option to most patients with SCA,97 although newer successful approaches may increase interest in this modality.98 Until something better becomes available that has a similar wide spectrum of efficacy and safety, hydroxyurea appears to be the best available treatment option for children and adolescents with SCA.
Acknowledgments
The author thanks William H. Schultz and Nicole A. Mortier for ongoing support and assistance in providing hydroxyurea treatment to more than 500 children with SCA over the past 15 years; colleagues at St Jude Children's Research Hospital for support and treatment of many young patients with SCA; Dr Thomas R. Kinney and Dr Sherri Zimmerman for early experiences and helpful discussions about hydroxyurea; Dr Clarice Reid for encouragement to pursue multicenter trials in SCA; and Dr Wendell F. Rosse for decades of guidance and mentoring toward a career in hematology.
This work was supported by the National Institutes of Health (U01-HL078787, R01-HL090941, U54-HL070590, N01-HB07155) and the American Syrian Lebanese Associated Charities.
National Institutes of Health
Authorship
Contribution: R.E.W. wrote the article.
Conflict-of-interest disclosure: The author declares no competing financial interests.
Correspondence: Russell E. Ware, Department of Hematology, 262 Danny Thomas Pl, MS 355, St Jude Children's Research Hospital, Memphis, TN 38105-3678; e-mail: russell.ware@stjude.org.